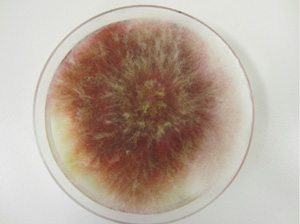
Figure 1. Mycelium of Fusarium graminearum on artificial growth media.
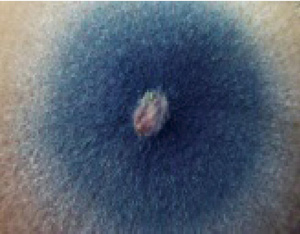
Figure 5. Mycelium of Fusarium virguliforme on artificial growth media

G2181
Major Fusarium Diseases on Corn, Wheat, and Soybeans in Nebraska
Fusarium species are associated with diseases of corn, wheat, and soybean, causing significant yield loss in Nebraska. Some produce mycotoxins that are harmful to humans and animals.
Bo Liu, Cropping Systems Disease Management Specialist
Loren J. Giesler, Plant Pathologist
Tamra A. Jackson-Ziems, Plant Pathologist
Stephen N. Wegulo, Plant Pathologist
Robert M. Harveson, Plant Pathologist
Kevin A. Korus, Extension Educator
Robert N. Klein, Western Nebraska Crops Specialist
- Fusarium graminearum (Gibberella zeae)
- Fusarium verticillioides (formerly Fusarium moniliforme)
- Fusarium virguliforme
- Overall Management of Fusarium Diseases
- Major Fusarium Diseases on Corn, Wheat, and Soybean in Nebraska
- Summary
Fusarium graminearum (Gibberella zeae)
F. graminearum (Figures 1 and 2) is an important pathogen of both corn and wheat at seed, seedling, and mature stages. F. graminearum causes several diseases, such as Gibberella stalk rot, ear rot, and kernel rot in corn; head blight (scab) of wheat; and seed rot and seedling diseases in both corn and wheat. Wheat-corn rotation is a popular dryland (non-irrigated) cropping system, and increases both wheat and corn diseases caused by F. graminearum.
|
 |
|
| Figure 1. Mycelium of Fusarium graminearum on artificial growth media. | Figure 2. Microscopic view of spores (conidia) of Fusarium graminearum. |
Fusarium verticillioides (formerly Fusarium moniliforme)
F. verticillioides (Figures 3 and 4) is an important economic pathogen causing stalk rot, ear rot, and kernel rot of corn. It is a different species from F. graminearum. Fusarium stalk rot in corn can be easily confused with Gibberella stalk rot, which can produce reddish discoloration of the internal stalk tissues.
 |
|
|||
| Figure 3. Mycelium of Fusarium verticillioides on artificial growth media. |
Fusarium virguliforme
Fusarium virguliforme (Figures 5 and 6) (formerly Fusarium solani f. sp. glycines) is a unique Fusarium species causing sudden death syndrome (SDS) of soybean. It was first discovered in Arkansas in 1971.
|
 |
|||
| Figure 6. Microscopic view of spores (conidia) of Fusarium virguliforme. |
Multiple Fusarium Species Along or in Combination Cause Seed, Seedling, and Root Diseases
Multiple Fusarium species exist in soil. Some are common plant pathogens, which can damage seeds and seedlings and cause root rot. The following Fusarium species can cause seed and root rot on corn, wheat, and soybeans: F. oxysporum, F. solani, F. verticillioides, F. graminearum, F. culmorum, F. sublutinans, F. acuminatum, F. equiseti, F. merismoides, F. proliferaum, F. pseudograminearum, and F. semitectum. Usually, Fusarium infects plants in combination with Rhizoctonia, Phytophthora, and Pythium species, which kill seeds before germination and cause seedling death under suitable conditions for pathogens.
Most of the pathogenic Fusarium species are either soil-borne or seed-borne. The rest of the Fusarium species include saprophytic and endophytic (found within the plant without causing symptoms; for instance, F. verticillioides on corn). The majority of growers in Nebraska use a wheat-corn, corn-soybean, or corn-soybean-wheat rotation in combination with reduced-tillage or no tillage systems, which help prevent erosion and increase organic and soil water content. Crop residue left on the surface of the field will increase to some extent the diseases caused by Fusarium species. The wheat-corn rotation is used in pivot corners, so every three years the continuous irrigated corn is surrounded by wheat.
Overall Management of Fusarium Diseases
The pathogenic Fusarium species are soil- borne microbes that can survive in soil and crop residue for a long time. Fusarium pathogens constantly exist in soil and wait for the right conditions to infect plants. Many factors can lead to disease development.
Fusarium pathogens can easily penetrate and infect stressed plants, and plant stress can increase the incidence and severity of the diseases. Causes of stress to plants includes
- herbicide injury,
- foliar diseases,
- hail damage,
- drought, and
- soil with unbalanced fertility in macronutrients, nitrogen, and potassium.
Compacted soil also increases Fusarium diseases; therefore, minimizing soil compaction will help drainage, improve plant root growth, and reduce Fusarium diseases. If Fusarium infected grain is used as seed, fungicide seed treatments can be used to reduce seed rot and seedling diseases caused by Fusarium spp. Fungicide seed treatments can also reduce buildup of the Fusarium pathogens in soil. However, seed treatment is not suitable for the control of SDS of soybean. Cultural practices such as plowing can reduce Fusarium diseases, but plowing can increase soil erosion and loss of soil moisture. Another cultural practice is crop rotation with non-host crops, such as wheat-corn with soybean-alfalfa rotation. Continuous cropping should be avoided if the Fusarium diseases are severe in a field, especially in reduced or no-till cropping systems. Again, SDS of soybean cannot by controlled by crop rotation. Using tolerant cultivars with different planting dates can help reduce losses caused by Fusarium diseases.
Major Fusarium Diseases on Corn, Wheat, and Soybean in Nebraska
Fusarium Diseases on Corn
 |
|||||
Disease |
Gibberella Stalk Rot | Gibberella Ear or Kernel Rot | Fusarium Stalk Rot | Fusarium Kernel or Ear Rot | Fusarium Root Rot |
| Pathogens | F. graminearum | F. graminearum | F. verticillioides | F. verticillioides | F. oxysporum, F. verticillioides F. graminearum |
| Symptoms and signs | Pink to red discoloration inside the stalk; may produce small, round, black reproductive structures called perithecia on the surface of the stalk (Figure 7) | Reddish mycelium on the ear, starting usually on the tip (Figure 8) | The pith disintegrates, white fungal growth may develop on outside of stalk; a pink discoloration inside rotted stalks; lacks visible reproductive structures (Figure 9) | White, pink, to lavender mycelium on kernels scattered around ear; some kernels may develop a “starburst” pattern (Figure 10) | Complexes symptoms, dark brown to black, discolored decaying or completely rotted roots (Figure 11) |
| Conditions | Warm and wet weather in late summer; stress such as drought, freezing and insect damage, or herbicide injury | Cool and wet weather within three weeks after silking | Warm and wet weather after silking; water stress and foliar diseases; insect or hail injury; imbalanced fertility (high N to K ratio) | Hot and dry weather | Cool wet weather; stress |
| Overwinter | Crop residue, seed and soil | Crop residue, seed and soil | Crop residue, seed and soil, infect through roots | Crop residue and soil | Crop residue and soil |
| Dispersal | Soil- and residue-borne hypha and spores through root or stalk infection | Soil-, air-, and residue-borne spores | Soil-borne hypha and spores | Soil-borne hypha and air-borne spores |
Soil-borne mycelium and spores through root infection |
| Toxins | Yes [vomitoxin (DON), zearalenone, T-2 toxin] | Yes [vomitoxin (DON), zearalenone, T-2 toxin] | Yes (Fumonisins) | Yes (Fumonisins) | Yes [depends on which pathogen(s)] |
Management |
|
|
|
|
|
Fusarium Diseases on Wheat
 |
||||
| Disease | Head Blight (scab) | Fusarium Seed and Foot Rot | ||
| Pathogens | F. graminearum | F. graminearum; F. culmorum | ||
| Symptoms and signs | Tan or brown discoloration at the base of a florets. Diseased spikelets become light tan or bleached. Orange clusters of spores on the glumes. Kernels are shriveled, white and chalky, develop a pink discoloration. (Figure 12) | Dark brown lesion around node of plants, whole stem base may become girdled by dark brown lesion. A cottony pink mycelium appear on stem base, produce white head when mature (Figure 13. Photo: Tim Paulitz, Washington State University) | ||
| Conditions | Intermediate to warm temperatures | Cool wet weather, reduced tillage, stress | ||
| Overwinter | Crop residue, seed and soil | Crop residue and soil | ||
| Dispersal | Spores carried by air current | Soil-borne mycelium and spores through root infection | ||
| Toxins | Yes (vomitoxin (DON), zearalenone) | No | ||
| Management |
|
|
||
Fusarium Diseases on Soybean
 |
||
| Disease | Sudden Death Syndrome (SDS) | Fusarium Seed, Root Rot, and Wilt |
| Pathogens | Fusarium virguliforme | More than 10 Fusarium spp. |
Symptoms and signs |
Early symptom are chlorotic mottling and crinkling of leaves, later lead tissue between the major veins turns yellow to brown. Interveinal cholorosis and necrosis is typical (Figure 14) | Seed decay. Brown to black cortical decay or vascular discoloration in roots. If root rot become severe, soybean plants develop foliar symptoms including stunting yellowing, wilting and defoliation (Figure 15. Photo: Dr. Daren Mueller, Iowa State University) |
| Conditions | Cool wet weather, reduced tillage, stress such as infection by SCN | Cool wet weather, reduced tillage, stress |
| Overwinter | Crop residue and soil, infect through roots | Crop residue and soil |
| Dispersal | Soil-borne hypha and spores | Soil-borne mycelium and spores through root infection |
| Management |
|
|
Summary
Since there is a lack of highly resistant or tolerant cultivars to Fusarium pathogens, integrated disease management should be adopted to manage Fusarium diseases. The following management strategies could be used to reduce losses caused by Fusarium spp.
- Minimize stress and injury by herbicides, foliar diseases, hail damage or drought
- Optimize soil fertility level
- Minimize soil compaction
- Seed treatment
- Crop rotation
- Planting tolerant cultivars
This publication has been peer reviewed.
Visit the University of Nebraska–Lincoln Extension Publications website for more publications.
Index: Plant Diseases
General
Issued December 2012